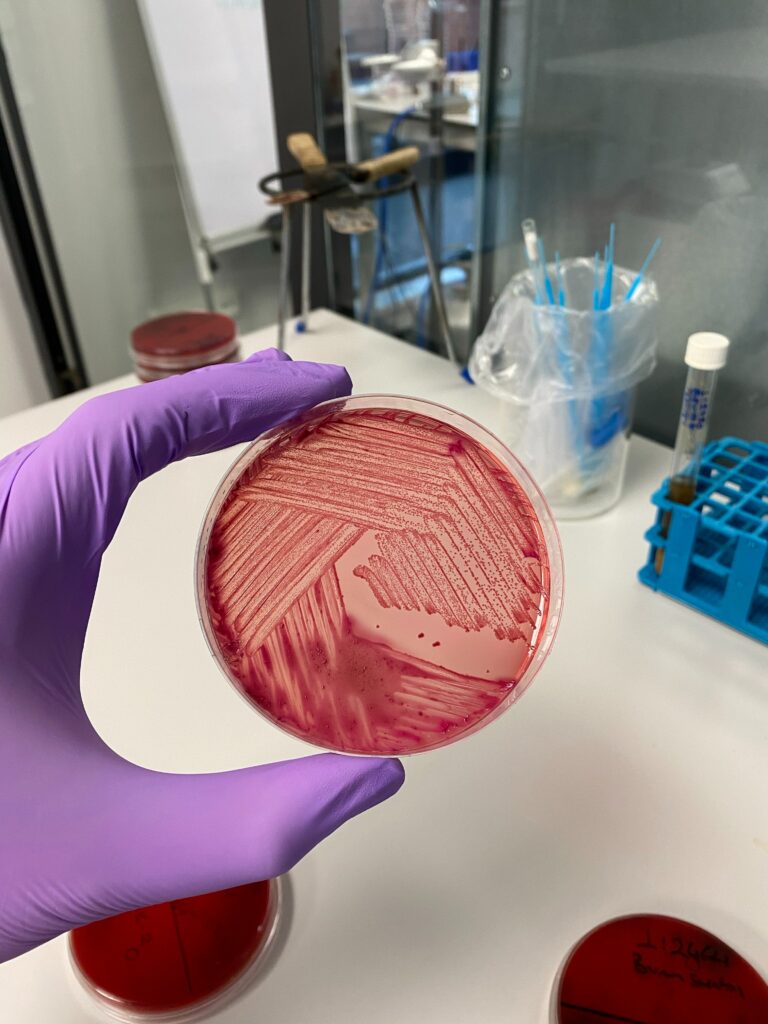

Badania mikrobiologiczne opakowań bezpośrednich w wytwarzaniu produktów leczniczych i kosmetyków

Opakowania dla preparatów farmaceutycznych muszą zostać zaprojektowane i wyprodukowane w taki sposób, aby zapewnić bezpieczeństwo produktu gotowego. Jakość mikrobiologiczna opakowań bezpośrednich jest zatem istotnym, który należy kontrolować. W wykładzie przedstawimy uwagi dotyczące kwalifikacji dostawcy opakowań, rodzaje stosowanych opakowań bezpośrednich i…